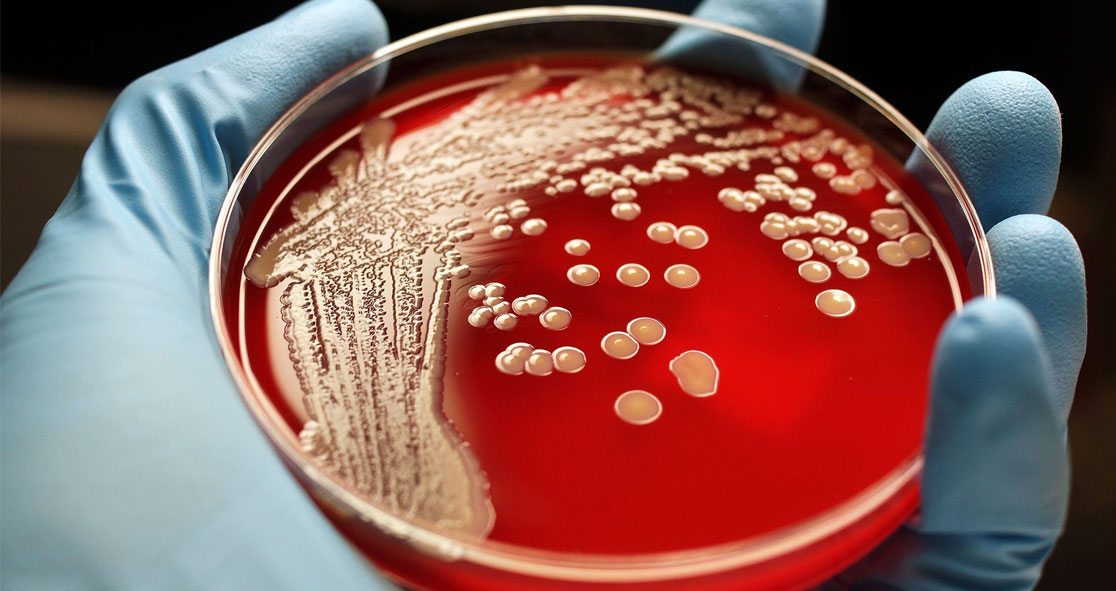

In an article published in the Infectious Disease Special Edition (IDSE), Glenn Tillotson, Ph.D., has mentioned that antibiotic resistance continues to rise despite efforts to reverse it – thanks to inappropriate use of antimicrobial drugs.
Tillotson has more than 30 years of pharma and biotech experience. He also has sound experience in global medical affairs and strong advocate for antibiotic development.
Using antibiotics inappropriately, unnecessarily, or excessively could lead to resistance, which means the drug will not work or will be ineffective if given the next time.
When it comes to the duration of treatment (DOT), there have been several discussions in which “we are reminded that a week is 7 days, as defined by Constantine the Great almost 2,000 years ago, and this is one of the most frequently prescribed periods of antibiotic use.” However, there is a lack of evidence to support this DOT.
Over the past four decades, multiple studies have examined the efficacy of various DOTs with their effects on bacterial infections, especially urinary tract infections (UTIs).
Different antibiotics have different doses. Research has provided evidence that 3 to 5 days of fluoroquinolones therapy in simple cystitis was enough for antibiotics such as ciprofloxacin or levofloxacin, given once or twice daily, according to Tillotson.
“Single dosing was inadequate, with efficacy rates usually around 80% or less compared with longer courses yielding outcomes of 90% or better,” he wrote. “Complicated UTIs, which include pyelonephritis, were studied by Peterson et al10 who compared levofloxacin 750 mg once daily for 5 days with ciprofloxacin given as either an IV or oral formulation at 400/500 mg twice daily for 10 days.”
“The shorter course was non-inferior,” he continued. “Sandberg et al compared ciprofloxacin over 2 periods in women with acute pyelonephritis.11 Again, the shorter treatment was non-inferior, and the longer course was associated with oral candidiasis.”
Experts have also been studying the antibacterial treatment of community-acquired pneumonia (CAP) at various doses and durations.
The treatment of acute bacterial skin or soft tissue infection typically depends on the type and site of infection. For instance, an abscess requires incision and drainage along with antibiotic therapy, but until a recent study by Lake et al,15 the effect of DOT was uncertain,” Tillotson wrote.
Some guidelines provide recommendations for DOT, but the enforcement is arbitrary,” Tillotson explained in the article.
Infectious disease experts Dr. Brad Spellberg and Dr. Louis Rice says, “Change is scary, and medicine is a conservative profession.” However, it is incumbent on our oath to “first do no harm” as we select an antibiotic and factor in the appropriate length of course. For more information on the duration of antibiotic treatment, read the article titled “How Long Is Long Enough? The Ongoing Saga of Antibiotic Therapy,” published Monday on IDSE.